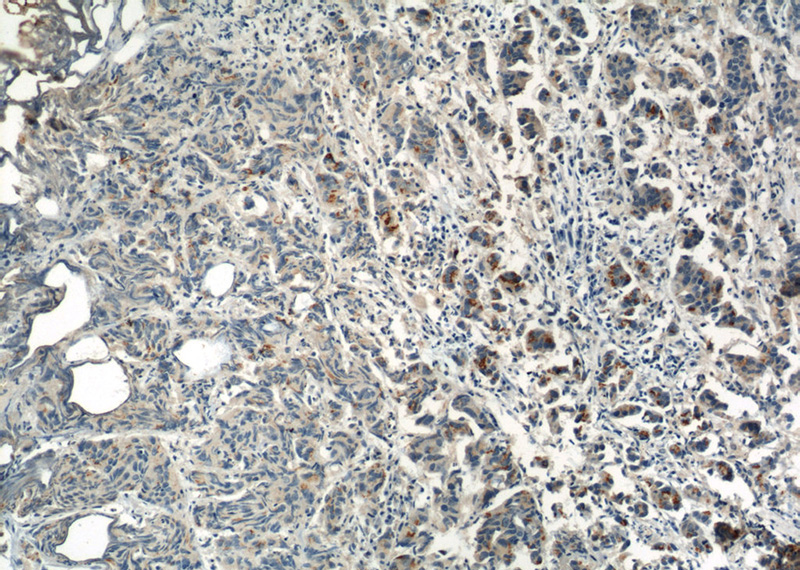
Immunohistochemistry of paraffin-embedded human prostate cancer slide using Catalog No:107472(PIK3R1 Antibody) at dilution of 1:50
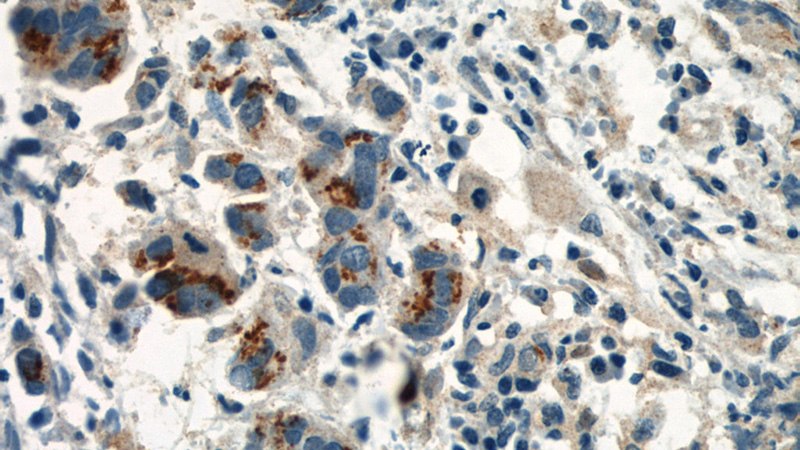
Immunohistochemistry of paraffin-embedded human prostate cancer slide using Catalog No:107472(PIK3R1 Antibody) at dilution of 1:50
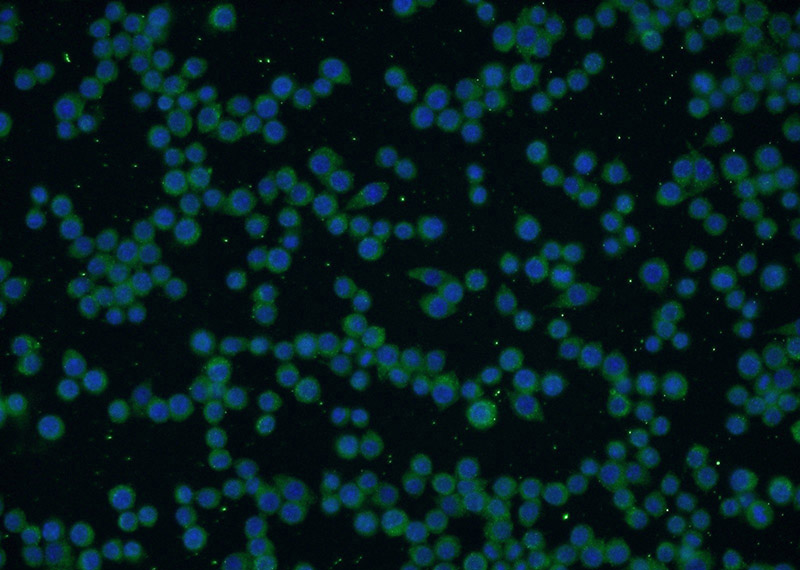
Immunofluorescent analysis of RAW 264.7 cells using Catalog No:107472(P85a; PIK3R1 Antibody) at dilution of 1:50 and Alexa Fluor 488-congugated AffiniPure Goat Anti-Mouse IgG(H+L)

-
Product Name
PI3K p85(alpha) antibody
- Documents
-
Description
PI3K p85(alpha) Mouse Monoclonal antibody. Positive IP detected in RAW 264.7 cells. Positive WB detected in Human brain. Positive IF detected in RAW 264.7 cells. Positive IHC detected in human prostate cancer tissue, human skeletal muscle tissue. Observed molecular weight by Western-blot: 85 kDa, 55 kDa
-
Tested applications
ELISA, WB, IHC, IF, IP
-
Species reactivity
Human, Mouse; other species not tested.
-
Alternative names
GRB1 antibody; p85 antibody; p85 ALPHA antibody; PI 3 Kinase p85 alpha antibody; PI 3-kinase p85α antibody; PI3 kinase subunit p85 alpha antibody; PI3K p85(alpha) antibody; PI3K regulatory subunit alpha antibody; PIK3R1 antibody
-
Isotype
Mouse IgG2a
-
Preparation
This antibody was obtained by immunization of PI3K p85(alpha) recombinant protein (Accession Number: NM_181504). Purification method: Protein A purified.
-
Clonality
Monoclonal
-
Formulation
PBS with 0.02% sodium azide and 50% glycerol pH 7.3.
-
Storage instructions
Store at -20℃. DO NOT ALIQUOT
-
Applications
Recommended Dilution:
WB: 1:500-1:5000
IP: 1:200-1:2000
IHC: 1:20-1:200
IF: 1:20-1:200
-
Validations

human brain tissue were subjected to SDS PAGE followed by western blot with Catalog No:107472(PIK3R1 antibody) at dilution of 1:1000
Immunohistochemistry of paraffin-embedded human prostate cancer slide using Catalog No:107472(PIK3R1 Antibody) at dilution of 1:50
Immunohistochemistry of paraffin-embedded human prostate cancer slide using Catalog No:107472(PIK3R1 Antibody) at dilution of 1:50

IP Result of anti-P85a; PIK3R1 (IP:Catalog No:107472, 5ug; Detection:Catalog No:107472 1:500) with RAW 264.7 cells lysate 1480ug.
Immunofluorescent analysis of RAW 264.7 cells using Catalog No:107472(P85a; PIK3R1 Antibody) at dilution of 1:50 and Alexa Fluor 488-congugated AffiniPure Goat Anti-Mouse IgG(H+L)
-
Background
Phosphatidylinositol 3-kinase (PI3K) plays an important role in the metabolic actions of insulin and is required for adipogenesis. The PI3K pathway has also been identified as an important player in cancer development and progression. The Class IA PI3K heterodimer, which is composed of a P110 catalytic subunit and a P85 regulatory subunit, is activated upon association of the P85 subunit with upstream adaptor proteins or receptor tyrosine kinases. Mutations in PIK3R1 are implicated in cases of breast cancer and associated to SHORT syndrome.
-
References
- Wu ZH, Tao ZH, Zhang J. MiRNA-21 induces epithelial to mesenchymal transition and gemcitabine resistance via the PTEN/AKT pathway in breast cancer. Tumour biology : the journal of the International Society for Oncodevelopmental Biology and Medicine. 2015.
Related Products / Services
Please note: All products are "FOR RESEARCH USE ONLY AND ARE NOT INTENDED FOR DIAGNOSTIC OR THERAPEUTIC USE"
